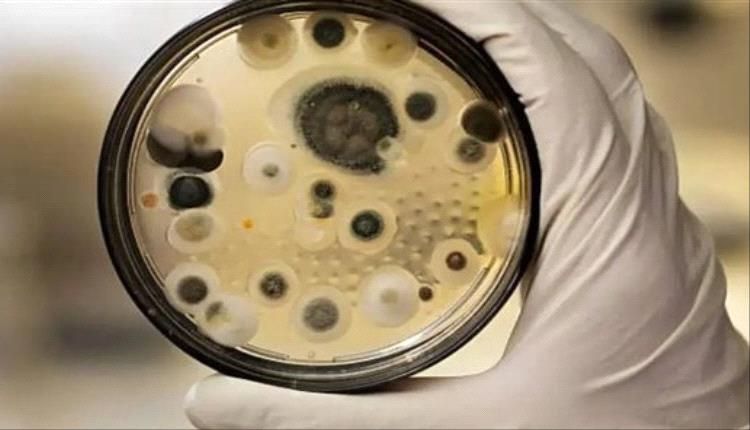
دراسة تحذر من انتشار فطر قاتل مقاوم للأدوية في جميع أنحاء العالم

ان الان تتابع ترند اليوم ويتحدث عن دراسة تحذر من انتشار فطر قاتل مقاوم للأدوية في جميع أنحاء العالم والان مع التفاصيل
زهرة اسماعيل - الرياض - الأربعاء/31/ديسمبر/2025 - 08:37 م
بيان تأييد صادر عن الإتحاد العام لنقابات عمال الجنوب تابع الإتحاد العام لنقابات عمال الجنوب بإهتمام بالغ البيان الصادر عن أعضاء مجلس القيادة الرئاسي:
الأربعاء/31/ديسمبر/2025 - 07:36 م
نفى رئيس الجمعية الوطنية للمجلس الانتقالي الجنوبي، علي الكثيري، صحة الشائعات المتداولة بشأن انسحاب القوات الجنوبية الحكومية من وادي وصحراء حضرموت، مؤك
الأربعاء/31/ديسمبر/2025 - 07:25 م
سجل الريال اليمني استقرار مقابل العملات الأجنبية، مساء اليوم الأربعاء 31 ديسمبر 2025م ، في أسواق الصرف بالعاصمة عدن والمحافظات المحررة. وحسب مصادر مصر
الأربعاء/31/ديسمبر/2025 - 05:51 م
وجهت الولايات المتحدة، صفعة قوية لرئيس مجلس القيادة رشاد العليمي، ووزير الخارجية شائع الزنداني، حيث لم تشير أو تؤكد على دعم المجلس والقرارات الأحادية



